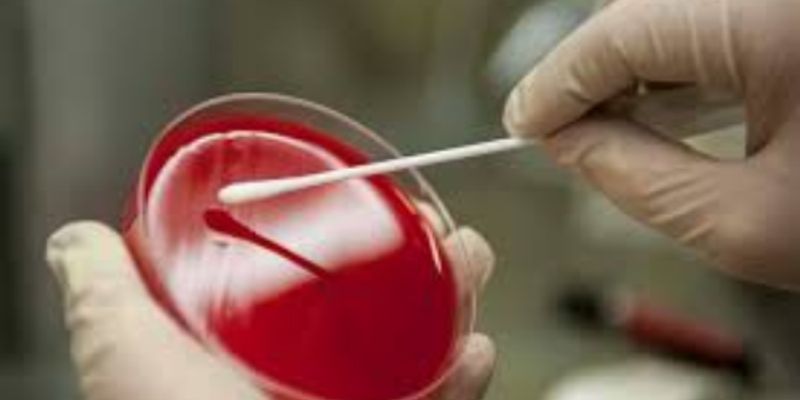

In Vitro
In Vitro: refers to a medical test or experiment/procedure that is conducted in a laboratory within the confines of a test tube or laboratory dish. This is not to be confused with the term in vivo, which is a medical test or procedure that is performed on or in a living organism.
What's Popular in In Vitro
-
FEB 11, 2025Drug Discovery & DevelopmentResearchers have developed light-sensitive chemicals that can eliminate tumors in vivo in mouse models of breast cancer ...Written By: Annie LennonJAN 25, 2024Cannabis SciencesA recent review investigated the potential for cannabidiol (CBD), a non-psychoactive compound found in cannabis, to alle ...Written By: Annie LennonNOV 22, 2023ImmunologyA characteristic of tumors includes the ability to avoid the immune system. In many cases tumors can progress without de ...Written By: Brian G. MorrealeNOV 13, 2023Health & MedicineDiabetes the Disease Diabetes is a chronic health condition that affects the metabolism of individuals. Diabetes is caus ...Sponsored By: Thermo Fisher ScientificNOV 07, 2023ImmunologyPublished by Beata Boczkowska, Ph.D. Interleukin-18 (IL-18) is an effective pro-inflammatory cytokine for the host defen ...Sponsored By: MBL International
FEB 11, 2025
Drug Discovery & Development
Researchers have developed light-sensitive chemicals that can eliminate tumors in vivo in mouse models of breast cancer
...
Written By:
Annie Lennon
JAN 25, 2024
Cannabis Sciences
A recent review investigated the potential for cannabidiol (CBD), a non-psychoactive compound found in cannabis, to alle
...
Written By:
Annie Lennon
NOV 22, 2023
Immunology
A characteristic of tumors includes the ability to avoid the immune system. In many cases tumors can progress without de
...
Written By:
Brian G. Morreale
NOV 13, 2023
Health & Medicine
Diabetes the Disease Diabetes is a chronic health condition that affects the metabolism of individuals. Diabetes is caus
...
Sponsored By:
Thermo Fisher Scientific
NOV 07, 2023
Immunology
Published by Beata Boczkowska, Ph.D. Interleukin-18 (IL-18) is an effective pro-inflammatory cytokine for the host defen
...
Sponsored By:
MBL International
OCT 17, 2023
Cancer
Cutaneous squamous cell carcinoma (cSCC) is a common form of skin cancer often caused by chronic exposure to ultraviolet
...
Written By:
Greta Anne
OCT 17, 2023
Cancer
Introduction CAR-T therapies represent a new successful strategy for the treatment of hematological malignancies; howeve
...
Sponsored By:
Sino Biological
OCT 08, 2023
Neuroscience
Researchers have identified a correlation between caffeine consumption from tea and coffee and a lower risk of Parkinson
...
Written By:
Annie Lennon
SEP 11, 2023
Microbiology
Introduction Mycoplasma contamination is prevalent in cell culture labs: in one study, researchers identified mycoplasma
...
-
mRNA?based products are rapidly growing in the biotherapeutics space. Important considerations need to be made to develop a process for mRNA synthesis that consistently generates high?yield...Speaker: Daniel DixonPresented at: Drug Discovery & Development Virtual Event Series 2024
Sponsored By: Thermo Fisher Scientific
Diosgenin is a botanical steroidal saponin with anti-inflammatory, antioxidant, anti-thrombotic, anti- apoptotic, anti-depressant, and anti-nociceptive properties. However, it's unknown...
Speaker:
Dr. Md. Mahbubur Rahman, DVM, PhD
Presented at: Drug Discovery & Development Virtual Event Series 2024
Proliferation biomarkers are proteins that are up-regulated in growing cells. Immunological staining of tumor tissue can provide an indication of the aggressivity of the tumor and provide in...
FEB 08, 2024 | 10:00 AM
High-content screening (HCS) is an imaging-based, multi-parametric strategy used in drug development that generates rich datasets through multiplexing strategically chosen fluorescent dyes a...
JAN 23, 2024 | 10:00 AM
Organoid technologies are increasingly being used as in vitro models of human development and disease because they exhibit morphogenetic, structural and functional properties that recapitula...
Speaker:
Kalpana Barnes
mRNA?based products are rapidly growing in the biotherapeutics space. Important considerations need to be made to develop a process for mRNA synthesis that consistently generates high?yield...
Speaker:
Daniel Dixon
Presented at: Drug Discovery & Development Virtual Event Series 2024
Sponsored By: Thermo Fisher Scientific
Sponsored By: Thermo Fisher Scientific
Diosgenin is a botanical steroidal saponin with anti-inflammatory, antioxidant, anti-thrombotic, anti- apoptotic, anti-depressant, and anti-nociceptive properties. However, it's unknown...
Speaker:
Dr. Md. Mahbubur Rahman, DVM, PhD
Presented at: Drug Discovery & Development Virtual Event Series 2024
Proliferation biomarkers are proteins that are up-regulated in growing cells. Immunological staining of tumor tissue can provide an indication of the aggressivity of the tumor and provide in...
FEB 08, 2024 | 10:00 AM
High-content screening (HCS) is an imaging-based, multi-parametric strategy used in drug development that generates rich datasets through multiplexing strategically chosen fluorescent dyes a...
JAN 23, 2024 | 10:00 AM
Organoid technologies are increasingly being used as in vitro models of human development and disease because they exhibit morphogenetic, structural and functional properties that recapitula...
Speaker:
Kalpana Barnes
DEC 12, 2023 | 8:00 PM
Embryonic epicardium is crucial for normal heart morphogenesis. The tissue originates from the proepicardial organ, with cells migrating to form the outer mesothelial layer, giving rise to n...
DEC 12, 2023 | 7:00 AM
An estimated 48.5 million couples suffer from infertility worldwide, driving up usage of assisted reproductive technologies around the globe. As a result, preimplantation genetic testing (PG...
Speaker:
Anil Biricik, PhD
, Sandrine Chamayou, PhD
, Prof. Volkan Baltaci, MD, PhD
, Alok Tomar, PhD
Sponsored By: Thermo Fisher Scientific
DEC 07, 2023 | 10:00 AM
C.E. CREDITS
Lateral flow assay applications have become increasingly diverse in a post-pandemic world, and the areas of infectious disease and oncology continue to be at the forefront. In both areas, th...
NOV 29, 2023 | 9:00 AM
Tumor genomic profiling can be complicated, especially for diseases that commonly have multiple different genomic biomarkers of interest, such as non-small cell lung cancer (NSCLC) and color...